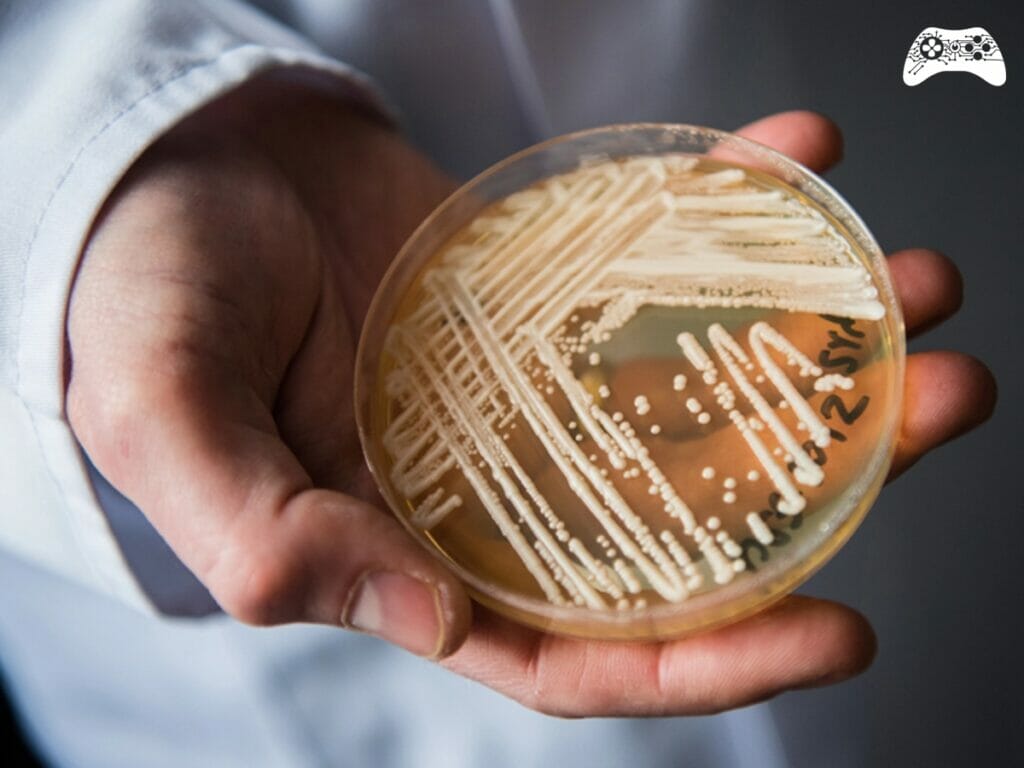
Candida auris

O jogo The Last of Us, assim como a série da HBO Max, trouxeram à tona uma das maiores epidemias para o universo da ficção: um superfungo. Em The Last of Us o fungo é baseado na espécie Cordyceps, que é conhecido pela capacidade de parasitar insetos, como formigas, e conseguir controlar o comportamento do hospedeiro, que se torna um tipo de “zumbi”.
Veja também:
E nos jogos, assim como na sua adaptação, este fungo conseguiu evoluir e controlar a mente dos seres humanos. Mas existe algo perigoso e real que tem assustado a comunidade científica. Conforme relatado pelo Terra, pesquisadores da Fundação Oswaldo Cruz (Fiocruz) identificaram o que seria o maior surto do ‘superfungo’ Candida auris no Brasil.
Através de um estudo, foram identificados 48 casos da doença entre novembro de 2021 e fevereiro de 2022 em Recife, capital de Pernambuco. Segundo ainda o site Terra, o Ministério da Saúde não havia relato de nenhum caso de infecção pelo fungo até janeiro de 2020. O Candida auris é considerado emergente na escala de ameaça à saúde global.
Ele foi identificado pela primeira vez em humanos em 2009, no Japão. O que torna esse fungo assustador, é que de 30 a 60% dos pacientes infectados morreram devido ao Candida auris. O motivo é que a infecção é resistente a medicamentos e apresenta tolerância a temperaturas elevadas de 37°C a 42°C, algo realmente assustador
Conforme relatado pelo CNN, essas características aumentam o risco de surtos hospitalares, uma vez que a colonização e as infecções podem ter origem em fontes ambientais, como dispositivos médicos contaminados e mãos de profissionais de saúde. O fungo pode causar infecção na corrente sanguínea e outras infecções invasivas que podem ser fatais, principalmente em pacientes imunocomprometidos ou com comorbidades.
Outro aspecto negativo é que os pacientes podem permanecer colonizados por esse microrganismo por muito tempo, sem infecção, favorecendo a propagação para outras pessoas e a ocorrências de surtos em serviços de saúde.
O Candida auris
Originalmente habitando apenas pântanos, o fungo sofreu pressão pelo aumento global da temperatura, e através da seleção natural, migrou para as aves e então para os humanos, chegando no Brasil em 2020, em uma paciente de 59 anos, em Salvador.